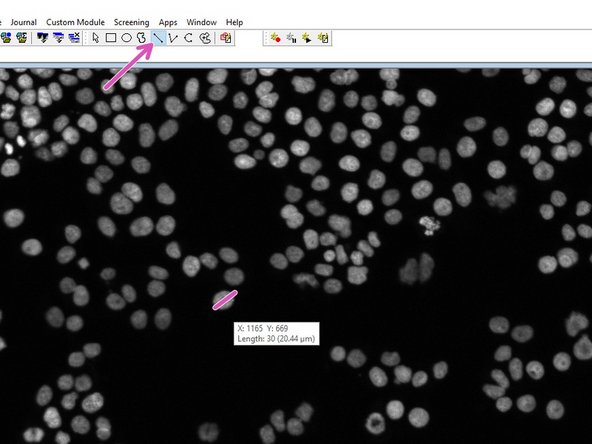
Choose how to display the results (we recommend &quot;New&quot;).
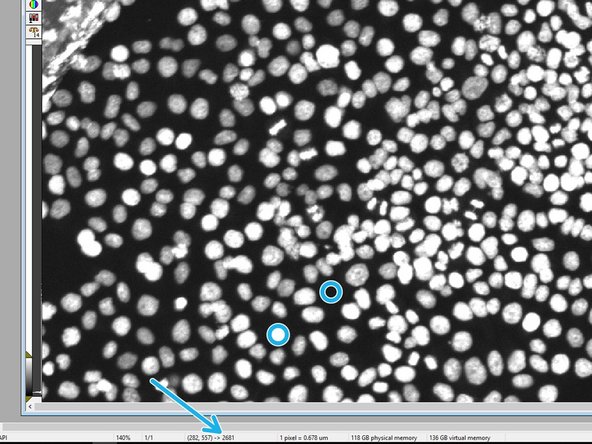
In the drawing toolbar, choose &quot;Line&quot; to measure the width of a few nuclei by clicking on one end of the cell and by placing the mouse over the diameter and getting the distance.

Introduction
This guide of the Center for Microscopy and Image Analysis explains how to count nuclei in HCS images acquired with the HCS - MD ImageXpress Confocal HT.ai and export the results.
NOTE 1: It is made for single-timepoint, multi-site, and multi-well acquisition for one channel (DAPI). Please adapt it to your own needs if you have different acquisition settings.
Note 2: Think beforehand how to design your plate. The data will be sorted by well A1-A12, B1-B12 etc.
-
-
Start the "MetaXpress" software either on Special VM B or on the dedicated Special MetaXpress VM.
-
Login with the same name and password as on the machine.
-
-
-
Go to "Screening" and select "Review Plate Data [DB]".
-
In the "Review Plate Data" window, click "Select Plate" to choose your plate to be analyzed.
-
Your plates are first ordered according to the acquisition date. Double-click to open the folder.
-
The different plates acquired on that day will appear below.
-
"Select" will open the respective plate data.
-
-
-
The plate format shows up. "-" indicates that these wells were imaged.
-
If you have run an analysis on this plate before, you can hide the values (Low Pressure) by unclicking "Show values" in the "Display tab".
-
For a montage, mark the corresponding wells, define the sites per well and select a channel for display.
-
For a high-resolution image of one site in a well, right-click on the corresponding well.
-
Please note that by right-click you will also automatically mark the cell for analysis.
-
-
-
In this example, a previous analysis has been performed on the plate.
-
Select your channel to be displayed and analyzed.
-
In the "Run Analysis" tab, under "Analysis" select "<Count Nuclei>".
-
If you already have saved settings, you may proceed to the next step.
-
Please do not overwrite other users settings!
-
To create your own settings, click on "Edit List" and "New Settings" with your specification.
-
Click on "Configure Settings" to adjust the segmentation parameters.
-
-
-
Choose your channel for the segmentation: "DAPI".
-
Choose how to display the results (we recommend "New").
-
In the drawing toolbar, choose "Line" to measure the width of a few nuclei by clicking on one end of the cell and by placing the mouse over the diameter and getting the distance.
-
Measure a few cells and use these values for the "Approximate min./max. width" for segmentation.
-
Hover over regions of cells and background and check the intensity in order to choose the segmentation parameter "Intensity above local background".
-
Click "Test Run" to test the input settings.
-
-
-
When the analysis is done for your test image, an overlay of the segmentation will be shown in red together with your grayscale image. Additionally, a color-coded segmentation image and cell-by-cell results will be shown.
-
Show/hide the overlay to judge the quality of the results.
-
If necessary, go back and adjust the input parameters to improve the segmentation.
-
If you are happy with the result, click "Save Settings".
-
It might be worth checking for a few images whether the input parameters work, especially when the size of the nuclei or the intensity greatly vary within your plate.
-
In order to check a different image of the same plate, go to the "Review Plate Data" tab and right-click on a different well. Do a "Test Run" again and judge the result.
-
-
-
You can now run the segmentation algorithm either onthe whole plate or on on a selection.
-
If you want to run on a selection, select the corresponding wells by right-click (will appear green) and choose the sites per well.
-
If you re-run an algorithm on a plate (for the same wells), the old data can be overwritten. However, it might still be accessible for export (c.f. step 9).
-
Running the algorithm on a whole plate will take a while. When you open the plate again in the "Review Plate Data", you will see the entry "Low Pressure", which indicates that for this well an analysis has been performed.
-
-
-
In the "Display tab", choose for "Image Overlay": "Show cell Segmentation".
-
Use this button to show/hide the segmentation and judge the quality of the algorithm.
-
Go to the "Measurement tab" and choose the "Analysis" (if multiple were run on the same plate).
-
Choose the type of "Analysis" to be displayed.
-
E.g. "Total nuclei (CountNuclei)" gives the total number of nuclei determined by the "CountNuclei" algorithm.
-
Note: "CO2 Pressure Status" is the default, therefore "Low Pressure" as default value after analysis.
-
If you choose one site per well, the corresponding value for the site will be shown. If you choose all sites, an average (not total!) will be shown.
-
Click "Show Heat Map" to display your results as a heat map.
-
-
-
For data export, go to "Screening" and select "Plate Data Utilities [DB]".
-
Select "Export Measurements".
-
Select "Image Measurements" and click "OK".
-
"Image Measurement" will give you the measurements per image (e.g. total/average of nuclei), but will not provide information about the individual cells.
-
-
-
The measurements are first sorted according to analysis date for the plate (Measurement Set) and then for the plate (Name [Plate Info]).
-
Either double-click on the measurement or use the arrow to make it appear in the "Query" on the right.
-
Click "Next".
-
Click "Finish".
-
In "Rows" select "Well Name" with the Type "Image Measurement" by double-clicking so it appears on the right.
-
In "Columns" double-click on "Total Nuclei" to get the number of nuclei per image.
-
Click "OK".
-
-
-
Select your export folder.
-
Check "Export all measurements to one file" and define a File Name.
-
Select "Tab Delimited (Data only)".
-
Click "OK".
-
You will get a notification that the export was successful.
-
-
-
We can provide you with a basic analysis template for Excel.
-
In the "Data" tab, click "From Text/CSV".
-
Open the ".txt"-file generated in Step 9.
-
Check whether the format is correctly recognized and click "Load".
-
A new tab will appear with your well information and the number of detected nuclei.
-
If you have acquired multiple sites per well, the number of nuclei per site is displayed and therefore the well name listed repeatedly.
-
-
-
To start referencing the data, go back to the "Sheet1", click on cell "A2" and type "=".
-
Go to the data sheet (test2), and click on the first cell (A2) with a well name, with the reference appearing in the formula bar.
-
Press Enter to make the reference.
-
Repeat the same procedure for the counted nuclei by typing "=" in cell "B2" and referencing it to "C2" (Total Nuclei (CountNuclei)!) in data sheet.
-
Mark Cells "A2&B2" and extend the referencing by grabbing and dragging the lower right corner of the marked cells down to the maximum number of sites measured.
-
-
-
Specify the number of sites per well and number of wells.
-
This will automatically fill cells H2 and J2.
-
By grabbing the lower right corner of the two marked cells H2 and J2, drag to extend to your maximum well number.
-
Type in the number of wells to be averaged, the corresponding mean and standard deviation will appear and the histogram will fill itself.
-
Default is average of >1 wells including standard deviation. If you want to change it, use all the tools that Excel has to offer.
-
Here you can adjust your x-axis label.
-


![Go to "Screening" and select "Review Plate Data [DB]".](https://d3t0tbmlie281e.cloudfront.net/igi/zmb/tTLYLVHVfiIb4KAU.medium)

![For data export, go to "Screening" and select "Plate Data Utilities [DB]".](https://d3t0tbmlie281e.cloudfront.net/igi/zmb/PPnLHOEBYvBr6cDS.medium)


![The measurements are first sorted according to analysis date for the plate (Measurement Set) and then for the plate (Name [Plate Info]).](https://d3t0tbmlie281e.cloudfront.net/igi/zmb/HIchopUpLqnaLTWI.medium)












